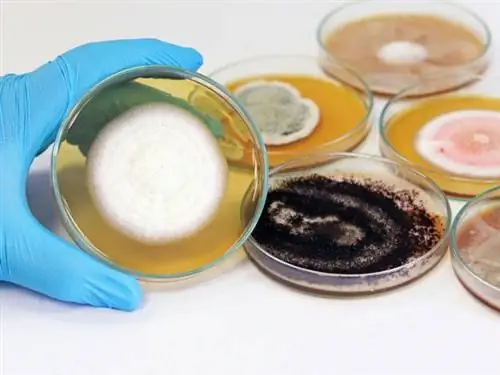
Стоимость устранения плесени Типы плесени

Затраты на устранение плесени обычно колеблются от 1 108 до 3 408 долларов США при средней стоимости 2 242 доллара США, но есть много факторов, которые могут повлиять на общую стоимость.

Основные моменты
- Обычный диапазон затрат на устранение плесени составляет от 1 108 до 3 408 долларов США, а средняя стоимость по стране составляет 2 242 доллара США.
- Точная стоимость этой услуги будет зависеть от местонахождения плесени в доме, типа присутствующей плесени, размера проблемы и стоимости рабочей силы.
- Домовладелец захочет позвонить специалисту по устранению плесени, если заметит признаки плесени, такие как затхлый запах или подозрительный рост на стенах после повреждения водой.
- Хотя домовладельцы могут самостоятельно справиться с плесенью на очень небольших участках, обычно рекомендуется нанять профессионала для устранения плесени из-за опасности для здоровья, которую она представляет.
Плесень - один из самых страшных кошмаров домовладельца: скрытый характер проблемы, потенциальная опасность вдыхания спор плесени, а также неизвестные факторы и затраты на удаление - все это делает плесень проблемой, которой нужно опасаться. На общую стоимость удаления влияет множество факторов, в том числе местонахождение и тип плесени, масштаб проблемы и тип необходимого исправления. Лечение плесени может быть таким же простым, как мытье с отбеливателем, или сложным, как удаление панелей гипсокартона и плитки для глубокой очистки под поверхностью, но независимо от того, насколько велика проблема с плесенью, есть способ ее исправить. Итак, сколько стоит устранение плесени? По данным Angi и HomeAdvisor, устранение плесени обычно обходится домовладельцам от 1 108 до 3 408 долларов, или в среднем 2 242 доллара.
Во всех домах есть плесень: важно понимать, что полное удаление каждой споры невозможно, поэтому термин «удаление плесени» относится к удалению определенного нароста, а не к возможности его обработки. дом полностью без плесени. Наличие плесени - это не показатель чистоты дома, а скорее наличие влаги, которую, вероятно, нужно исправлять. Оценка источника и размера проблемы помогает домовладельцам оценить, сколько им нужно будет потратить, чтобы удалить любую опасную плесень из дома.
Факторы при расчете стоимости ликвидации плесени

Важнейшими факторами, определяющими стоимость удаления плесени, являются местоположение, размер и тип плесени, а также стоимость рабочей силы в этом районе. Плесень, которая скрыта от глаз или труднодоступна, будет сложнее уменьшить, и поэтому ее удаление будет стоить дороже. Неудивительно, что большие наросты будут более дорогостоящими для удаления, как и некоторые типы плесени, которые устойчивы к средствам для удаления плесени, являются агрессивными распространителями или особенно опасны для дыхания.
Место в доме
Домовладельцы могут предположить, что плесень можно найти только в проклятых местах, но это не всегда так. По словам Дэвида Харли, владельца AdvantaClean of Badgerland, «плесень можно найти в любом месте дома. [Ему] просто нужны три вещи для роста: ему нужна температура где-то между 40 и 100 градусами, ему нужен источник пищи из органических материалов, таких как дерево, бумага, остатки пищи, растительная масса и т. д., и ему нужна влага».
В зависимости от местоположения плесени домовладельцы могут удалить ее с помощью уксуса, отбеливателя или спрея для удаления плесени. Избавиться от плесени на стене может быть довольно просто, но скрытые или труднодоступные места могут потребовать сноса или ползания подрядчика по подвалу или подполью. Местоположение определит наилучший способ удаления и необходимость найма одной из лучших компаний по удалению плесени.
- Чердак: По словам Харли, «[плесень] может быть вашим чердаком, поскольку зимой из жилого помещения поднимается теплый влажный воздух. и конденсируется на древесине на чердаке, потенциально может питать плесень». Удаление плесени на чердаке имеет широкий диапазон затрат по нескольким причинам. С одной стороны, чердаки, как правило, представляют собой открытые пространства с легким доступом, что может удерживать расходы ниже среднего диапазона от 1000 до 4000 долларов. Однако чердаки также часто темные, плохо проветриваются и подвержены воздействию влаги из вентиляционных отверстий и протечек в крыше.. Если проблема с плесенью на чердаке сохраняется, затраты на удаление могут достигать 7000 долларов, в дополнение к потенциальной необходимости ремонта крыши для устранения источника проблемы.
- Подвал: «В подвалах, как правило, прохладнее, а влага имеет тенденцию оседать в подвале в летнее время, вызывая конденсат на древесине в подвал, ведущий к потенциальному росту плесени», - объясняет Харли. Для плесени, растущей во влажном подвале, рекомендуется нанять профессионала для оценки и потенциального устранения проблемы. Отчасти это связано с тем, что, если нет явной протечки, может быть трудно найти источник плесени в подвале, а также потому, что он может быть скрыт за панелями или готовыми стенами; профессионал лучше справится с определением больших масштабов роста. В целом, профессиональная борьба с плесенью в подвале будет стоить от 500 до 3000 долларов, в дополнение к стоимости работ по гидроизоляции или герметизации стен фундамента.
- Воздуховоды: Воздуховоды могут содержать удивительно большое количество плесени и вызывают особую озабоченность, поскольку они распыляют споры по всему помещению. домой, поощряя рост в других областях. Трудно очистить протоки достаточно хорошо, чтобы удалить все споры, поэтому важна профессиональная помощь. Чистка воздуховодов стоит в среднем от 268 до 490 долларов. После удаления плесени более экономично планировать регулярную очистку воздуховодов один или два раза в год, чтобы предотвратить заселение новых спор.
- Гипсокартон: Борьба с простым ростом плесени на поверхности гипсокартона стоит в среднем около 1000 долларов, но гипсокартон пористый. Если рост плесени был там в течение длительного времени или если плесень проросла через гипсокартон сзади, возможно, для исправления потребуется удалить весь гипсокартон и все, что за ним, что может стоить до 20 000 долларов. или больше.
- Пространство для обхода: Пространства для обхода обычно ограничены по размеру, что означает, что общая площадь, подлежащая очистке, меньше. Однако ограниченный характер пространства также может означать, что восстановление занимает больше времени и требует больших затрат труда. Средняя стоимость удаления плесени из подвального помещения составляет от 500 до 2000 долларов США.
- HVAC и AC: Расходы, связанные с удалением плесени из системы HVAC, во многом зависят от типа системы в доме. Системы лучистого отопления, которые в основном закрытые, будут стоить от 1500 до 5000 долларов. Печи и кондиционеры с большим количеством воздуховодов, соединений и вентиляционных отверстий будут стоить в среднем от 3000 до 5000 долларов, а системы кондиционирования воздуха, которые постоянно извлекают влагу из воздуха и отводят ее из дома, будут стоить в среднем от 3000 долларов. и 10 000 долларов просто потому, что в самой системе очень много влаги, а также из-за количества вентиляционных отверстий, труб и воздуховодов, задействованных в восстановлении.
- Ванная: В то время как ванные комнаты обеспечивают идеальную среду для роста плесени, плесень, которая, скорее всего, будет расти изо дня в день. пар и конденсат обычно представляют собой отчетливо видимую поверхностную плесень, удаление которой обходится дешевле в среднем от 500 до 1000 долларов. Плесень, которая развивается за туалетным столиком или раковиной, за или под ванной, обычно в результате продолжающейся протечки., может стоить до 8 000 долларов из-за сноса и реконструкции, которые потребуются для достижения и удаления плесени и устранения основной причины влажности.
- Весь дом: Если существует серьезная проблема с плесенью во всем доме, обычно в результате наводнения или катастрофического повреждения водой, стоимость удаления значительна. Этот вид сокращения выбросов включает удаление и замену ковра, гипсокартона, тканей и мебели, а также оплату устранения любых источников ущерба от воды, которые все еще существуют. Средняя стоимость составляет от 10 000 до 30 000 долларов в дополнение к замене удаленных материалов.
Размер проблемы
Размер плесени влияет на стоимость ее удаления. По данным Агентства по охране окружающей среды США (EPA), домовладелец обычно может заниматься проектами по ликвидации плесени площадью менее 10 квадратных футов, если плесень не была вызвана сточными водами и у домовладельца нет респираторной чувствительности. Единственные затраты на ремонт своими руками - это очиститель от плесени и защитное снаряжение.
Если плесень распространилась далеко за пределы этого размера, работа может стоить от 10 до 25 долларов за квадратный фут, а если плесень глубокая и распространяется по широкой поверхности, цена ее удаления может быть и выше. Это одна из причин, по которой так важно избавляться от плесени, как только становится ясно, что есть проблема: даже если первоначальная проблема кажется слишком дорогой для решения, со временем проблема будет становиться все больше и дороже.
Тип формы
Хотя они могут выглядеть тревожно, поскольку быстро распространяются по поверхности, поверхностная плесень (которая остается поверх строительных материалов) легко удаляется, как правило, с помощью чистящих средств. Удаление такой плесени обходится дешевле, и домовладелец, который знает, как бороться с плесенью, может сделать это своими руками.
Плесень, которая разъедает поверхность и проникает в сердцевину гипсокартона, дерева и бетона, а также плесень, которая процветает под ковровым покрытием и за стенами, обходится дороже. Это связано с трудностями обнаружения и локализации проблемы, а также с необходимостью удаления или замены стен, потолков, полов и мебели. Кроме того, если плесень идентифицирована как черная плесень или другой особенно токсичный вид, ее удаление может быть более дорогим из-за необходимости в специалистах, защитном оборудовании для техников и последующем проветривании всего дома. По словам Харли, «самая опасная для вас плесень - это плесень, которая вызывает у вас проблемы со здоровьем. Поскольку любая плесень может быть потенциально аллергенной, патогенной или токсигенной, со всеми видами плесени следует обращаться осторожно и обращаться к профессионалам».
Труд, работа
Устранение плесени - это не работа для обычного мастера, каким бы квалифицированным он ни был. Так что же такое устранение плесени и почему оно стоит дороже? Компании по удалению плесени, которые предоставляют эту услугу, используют квалифицированных техников и высококачественное оборудование, чтобы обеспечить использование точных и подходящих методов удаления и проверить состояние роста плесени после завершения удаления. Затраты на рабочую силу будут включать время, затраченное на работу, но также будут включать стоимость высокоэффективного вакуумного оборудования и средств защиты - от перчаток до комбинезонов и масок с респираторами - по мере необходимости. Приблизительно 60 процентов стоимости удаления плесени приходится на оплату труда, а остальные 40 процентов приходится на материалы.
Это не означает, что домовладельцы должны автоматически решать самостоятельно удалять большой рост плесени; есть причина, по которой профессиональные компании используют очистители воздуха и защитное оборудование. Плесень не является косметической проблемой, и особенно с агрессивными или токсичными плесенями попытка решить большую проблему без профессионального опыта и оборудования, скорее всего, приведет к распространению плесени по дому, а не к ее удалению. Эти 60 процентов стоимости защищают дом и его жителей, привлекая опыт техников, которые могут безопасно восстановить дом до места, где жители могут безопасно дышать. Поиск по фразе «удаление плесени рядом со мной» даст домовладельцам более точное представление о затратах для их региона.
Дополнительные расходы и соображения
Решение серьезной проблемы с плесенью заключается не только в ее удалении; для крупномасштабного роста процесс восстановления может включать удаление значительных кусков гипсокартона, плитки и коврового покрытия. В процессе расчета стоимости устранения плесени эти дополнительные расходы могут резко возрасти. Некоторые службы восстановления также предоставляют услуги по восстановлению, и, хотя это здорово объединить различные части работы в один наем, рекомендуется запросить несколько оценок восстановительных работ. Если восстановление необходимо, скорее всего, восстановление будет стоить больше, чем само восстановление, поэтому сообразительный домовладелец не будет привязан к службе восстановления, обеспечивающей восстановление, до тех пор, пока объем необходимых работ не станет очевидным.
Устранение повреждений
Иногда повреждение от устранения плесени так же просто, как соскоб или растворение краски в области, где плесень была очищена, а стоимость восстановления поверхности такая же недорогая, как банка с краской. С другой стороны, удаление плесени за стеной душа может означать, что необходимо установить новый гипсокартон, плитку и затирку - гораздо более крупный и трудоемкий проект. Такая степень влажности также может означать, что деревянные стойки, поддерживающие стену, гниют, и их также следует осмотреть и отремонтировать.
В дополнение к ремонту поверхности инспектор по плесени или специалист по устранению плесени должны помочь домовладельцам определить источник роста плесени, и возможно, что плесень является результатом повреждения или протечки труб. В этом случае домовладельцам необходимо будет включить расходы на найм сантехника для устранения утечек до закрытия стены. Значительный ущерб, причиненный либо водой, которая способствовала росту плесени, либо процессом восстановления, может стоить от 2 000 до 20 000 долларов США.
Материалы
Материалы, необходимые для устранения повреждений, обычно составляют около 40 процентов от общей стоимости устранения плесени. Гипсокартон (вместе со стоимостью ленты, глины и отделочных материалов, кровельных материалов и материала для герметизации фундамента) может потребоваться для устранения повреждений, вызванных плесенью, и предотвращения проблем с влажностью в будущем. Кроме того, может возникнуть необходимость заменить ковровое покрытие, напольное покрытие и мягкую мебель, если тип плесени в доме распространяется на текстиль.
Стоимость устранения плесени по типу плесени
Существует более 100 видов плесени, которые обычно растут в домах. Некоторые из них мягкие и их легко чистить, в то время как другие агрессивны, живучи и могут быть смертельными. Агрессивные типы плесени могут быть более дорогими для удаления, поскольку они покрывают более широкую область и могут не так быстро реагировать на традиционные средства для уничтожения плесени. Так что же убивает плесень в доме? Токсичные плесени требуют тяжелых химикатов, квалифицированного применения и защитного снаряжения для рабочих, выполняющих удаление, поэтому затраты на удаление будут выше. Затраты на рабочую силу и испытания в районе проживания домовладельца также повлияют на общие расходы в зависимости от типа плесени: для обработки черной плесени может потребоваться техник, специализирующийся на удалении черной плесени, чтобы убедиться, что плесень удалена полностью и не распространяется повсюду. остальная часть дома.
Альтернария
Альтернариоз - один из наиболее распространенных видов наружной плесени. Когда он попадает в воздух или попадает внутрь на подошве обуви, он распространяется со взрывом, а в домах с высокой влажностью может расти под коврами и обоями. Диапазон цен на удаление может варьироваться от 700 до 6000 долларов в зависимости от того, насколько широко оно распространено.
Аспергиллы
Одна из самых распространенных комнатных плесеней, аспергилл - это плесень, на которой основан пенициллин, и она состоит из более чем 250 идентифицированных видов. Его легко заметить, так как он начинается как пушистый белый гриб, а затем меняет цвет по мере роста. Хотя он хорошо растет при низкой влажности и может распространяться на ткани и текстиль, его обычно легче чистить, потому что его видимое присутствие сразу заметно. Стоимость удаления варьируется от 700 до 6 000 долларов США.
Черная плесень
Черная плесень считается самой токсичной бытовой плесенью. К сожалению, это также одна из самых сложных форм для удаления. Плесень, которая обычно выглядит черной или темно-зеленой и слегка слизистой, окрашивает поверхности по мере роста и не поддается удалению. Кроме того, он растет в ДВП, бумаге и гипсокартоне, где его бывает трудно обнаружить. Важность полного удаления и токсичность спор делают удаление более дорогим: средняя стоимость составляет от 800 до 7000 долларов.
Виктор Коппола, старший строительный биолог и основатель GreenWorks Environmental, LLC, советует: «Если все правильно устранено и источник(и) проникновения влаги устранен, то вы можете быть уверены, что черный плесень не вырастет. Но поскольку мы имеем дело с условно-патогенными организмами, вам всегда нужно следить за окружающей средой, чтобы гарантировать, что условия не вернутся, которые могут способствовать повторному росту организма».
Хетомиум
Затхлый запах, сине-зеленый цвет и коричневые споры в форме футбольного мяча являются отличительными чертами хетомиума, который представляет собой плесень, часто остающуюся после сильного повреждения водой или длительной сырости в доме. Он имеет тенденцию расти в труднодоступных местах, под коврами, в воздуховодах и стенах. Некоторые виды канцерогенны. Это довольно легко исправить, когда рост небольшой (стоимостью около 600 долларов), но более крупные проблемы могут стоить до 5000 долларов.
Кладоспориум
Распространенный и широко распространенный кладоспориоз может расти практически на всех бытовых поверхностях. Обычно он не вызывает серьезных реакций у большинства людей, хотя у некоторых могут возникнуть незначительные симптомы аллергии. Удаление стоит в среднем от 700 до 6000 долларов.
Фузариоз
Fusarium - еще одна быстро распространяющаяся плесень, которая существует практически на любой поверхности. Он может вызывать инфекции ногтей или роговицы даже у здоровых людей, а также системные септические инфекции, если споры попадают в кровоток. Фузариоз часто встречается вблизи протечек воды, и его удаление является одним из самых дорогих проектов; рассчитывайте заплатить от 800 до 8 000 долларов.
Зеленая плесень
Зеленая плесень на самом деле представляет собой несколько разных видов плесени, объединенных в группы по цвету. Хотя зеленую плесень часто можно увидеть на таких продуктах, как хлеб или фрукты, она также может включать кладоспориоз и аспергиллы. Хроническое воздействие может вызвать проблемы с дыханием или приступы астмы. Стоимость восстановления варьируется в среднем от 700 до 6000 долларов США.
Серпула Лакриманс
Особенно живучий тип плесени, Serpula lacrymans черпает воду из источников, отличных от того, где он живет, поэтому лучше всего растет на высушенной древесине. Также известная как «сухая гниль», ее легко узнать по желтому цвету. К сожалению, его чрезвычайно трудно удалить, и он может нанести ужасный и широко распространенный ущерб, поскольку он продолжает расти. Это не вредно для человека, но может быть чрезвычайно вредным для дерева и строительных материалов в домах. Стоимость восстановительных работ обычно колеблется от 800 до 7000 долларов, но может быть намного выше, в зависимости от степени повреждения конструкции.
Улокладиум
Чаще всего Ulocladium является симптомом серьезного повреждения водой. Для роста ему требуется много влаги. Улокладиум распространяется очень быстро, и его обычно можно найти среди нескольких других разновидностей плесени. Его можно узнать по коричневому или серому цвету и замшевой текстуре. Домовладельцы, скорее всего, заплатят от 600 до 6000 долларов за устранение улокладиума.
Белая плесень
Белая плесень также представляет собой группу различных плесеней, собранных по окраске, и опасна из-за их способности сливаться с исходными материалами, таким образом распространяясь дальше, прежде чем их обнаружат. Поскольку их может быть труднее обнаружить на ранней стадии, проблема обычно распространяется шире, чем с большинством плесеней, к моменту их обнаружения, а затраты, как правило, смещаются в сторону верхней границы среднего диапазона от 700 до 6000 долларов.

Нужна ли мне обработка от плесени?
Плесень коварна. Хотя в идеале он каждый раз представлял бы собой очевидный нечеткий рост, это не так; Плесень предпочитает темные, влажные места для роста, что затрудняет ее обнаружение на ранней стадии. Когда требуется устранение плесени? Есть некоторые предупреждающие знаки, которые следует учитывать. Как только становится ясно, что есть проблема, пришло время выбирать между наймом профессиональной помощи или выполнением работы самостоятельно. В отличие от многих решений о том, стоит ли нанимать помощника или нет, при устранении плесени есть несколько четких указаний о том, когда это делать.
Признаки плесени
Признаки того, что в доме растет плесень, могут быть незаметными или очевидными. Знание тонких признаков затруднит их случайное забвение и позволит домовладельцу быстрее добраться до сути проблемы.
- Запах плесени: Есть много слов, которые могут описать запах скрытой плесени, включая влажный, пыльный, затхлый, землистый и мясной.. Аромат может быть слабым или резким. Если он слишком сильный, домовладельцы должны как можно скорее позвать на помощь. Но даже слабый запах плесени, который сохраняется в комнате, в которой никто не тревожился весь день, или который появляется, когда на улице идет дождь, может быть проблематичным. Этот запах может быть лучшим признаком того, что есть проблема, и стоит провести некоторое расследование. Домовладельцы могут проверить под раковинами, рядом с водосточными трубами и в других влажных местах дома. То, что проблема не видна, не означает, что ее не существует.
- Белые, черные или зеленые наросты на стенах: Существует несколько типов плесени, которые проявляются в виде пятен, крапин или пушистости. острова на стенах, потолках, полах или тканях. Опять же, их не следует отбрасывать как однократные отклонения, если только источник не очень очевиден. Если декоративная подушка была случайно оставлена под дождем, а затем лежала на крыльце в течение нескольких дней, и во влажных складках образовалась плесень, это, вероятно, не является признаком широко распространенной проблемы. Но если под окном, которое часто остается приоткрытым, со временем появляется узор из серых точек, это нужно исследовать.
- Проблемы со здоровьем: Часто ожидаются симптомы аллергии весной и летом. Но если эти симптомы появляются в неожиданное время или внезапно проявляются в течение более длительного периода времени, возможно, их вызывают споры плесени внутри дома, а не пыльца снаружи.
- Недавнее повреждение водой: Влага - это благо для плесени, поэтому любое недавнее событие, которое могло бы увеличить влажность или влажность в доме, повод проверить на наличие плесени. Даже если плесени не видно, вполне возможно, что рост мог формироваться вне поля зрения, особенно если избыток воды выдерживался в течение длительного периода времени.
- Деформация, отслаивание или обесцвечивание стен: Чем дольше рост плесени не контролируется, тем больший ущерб она может нанести гипсокартону. Поскольку гипсокартон пористый, плесень может привести к деформации и отслаиванию поверхности с течением времени, и домовладельцы могут заметить потемнение или обесцвечивание в некоторых областях. Для плиточных полов и стен потемнение затирки является еще одним признаком плесени.
Чувствительность к плесени
Для домовладельцев, которые уже знают, что у них аллергия или чувствительность к плесени, любой намек на затхлый запах или физические симптомы должен стать тревожным сигналом. Аллергены, вырабатываемые плесенью, могут вызывать симптомы от легких до тяжелых при прикосновении или вдыхании, и симптомы могут проявляться с задержкой. Плесень также может быть триггером для людей, страдающих астмой. Если трудно определить другой источник запаха или симптомов, самое время провести оценку плесени. Те, кто знает, что они чувствительны, не должны пытаться самостоятельно удалять даже небольшое количество грибка, чтобы не распространить споры в процессе удаления. Некоторые более токсичные виды плесени могут негативно сказаться на здоровье жильцов, даже если у них нет аллергии. Коппола объясняет некоторые симптомы воздействия плесени: «Более частые аллергические реакции, такие как зуд в глазах, насморк и сухой кашель, могут быть очень распространены. Но проблемы с памятью [проблемы], расстройства центральной нервной системы, быстрое увеличение или потеря веса или выпадение волос являются проблемами, тогда как обычно действуют более токсичные организмы».
Повсеместный рост
В то время как большинство домовладельцев время от времени сталкиваются с небольшим пятном плесени и обрабатывают его средством для уничтожения плесени или отбеливателем, EPA предлагает, чтобы все, что больше примерно 10 квадратных футов, должно быть профессионально оценено.
Наличие плесени в системе вентиляции и кондиционирования
Системы ОВКВ особенно подвержены образованию плесени. По своей природе они перемещают воздух и влагу с места на место в доме по темным извилистым воздуховодам с множеством щелей. Домовладельцу практически невозможно самостоятельно прочистить воздуховоды в своем доме. Поддержание системы в чистоте посредством регулярного технического обслуживания и очистки поможет предотвратить рост плесени, но как только плесень там появится, важно удалить ее как можно быстрее и тщательнее, прежде чем система распространит ее на другие части дома.
Необходимо устранить повреждения
Если плесень распространилась достаточно широко, чтобы повредить строительные материалы или потребовать удаления коврового покрытия или напольного покрытия, рекомендуется профессиональная санация. Выдергивание ковра с плесенью может распространить споры повсюду и создать отправные точки для новых колоний. Плесень, вросшая глубоко в стены, может потребовать дополнительной обработки стоек и обрамления за стенами; это помогает гарантировать, что проблема будет устранена до того, как домовладелец заменит материалы, и может помочь предотвратить немедленное повторное зарастание.

Ликвидация плесени: сделай сам или наймите профессионала
Для домов с площадью менее 10 квадратных футов плесени EPA сообщает, что это достаточно небольшая площадь, с которой домовладелец может справиться. Однако важно предостеречь, если плесень была вызвана загрязненной водой или у домовладельца аллергия. В этом случае домовладелец может обратиться в профессиональную службу по устранению плесени, чтобы решить эту проблему.
В случае заражения плесенью площадью более 10 квадратных футов или если домовладелец чувствует запах плесени, но не видит ее, профессионал может решить проблему плесени быстро и тщательно. Существует большая вероятность того, что проблема глубже, чем ожидалось, и вероятность того, что домовладелец создаст более серьезную проблему, выискивая и беспокоя невидимые колонии плесени, еще выше. Профессионалы обучены следовать тонким подсказкам, чтобы найти плесень, и найдут ее в таких местах, где большинство домовладельцев даже не подумали бы искать. Например, рост плесени в системе HVAC может привести к совершенно незаметному распространению аллергенов по всему дому. Профессионал также с большей вероятностью сможет найти источник влаги, и у него будет защитное оборудование для себя и очистители воздуха в доме, которые более эффективны и эффективны, чем те, которые доступны в магазине товаров для дома. Поскольку существует так много разновидностей плесени, которые оказывают широкий спектр физических воздействий как на людей, так и на строительные материалы, в этой ситуации действительно стоит нанять квалифицированных специалистов для полного удаления плесени и устранения любого полученного повреждения.
Как сэкономить на устранении плесени
Самый важный фактор в экономии средств на устранение плесени - действовать немедленно. Домовладельцы, которые отложили устранение плесени, скорее всего, в конечном итоге заплатят больше, как только они, наконец, найдут профессионала, поскольку велика вероятность того, что плесень распространилась. Проблема с плесенью заключается в том, что даже если сейчас это не имеет большого значения, она будет, и иногда в течение нескольких дней, если не будут приняты немедленные меры. Небольшой рост управляем; большой рост может быть разрушительным, как в финансовом отношении, так и в плане здоровья. Если присутствуют какие-либо признаки плесени, домовладельцы захотят действовать немедленно. Есть несколько других способов сэкономить деньги на стоимости устранения плесени.
- Сделайте дом неблагоприятным для роста плесени, быстро отремонтировав и устранив любые утечки или повреждения водой.
- Если площадь с плесенью составляет менее 10 квадратных футов, немедленно очистите ее с помощью имеющегося в продаже чистящего средства.
- В случае больших площадей или скрытой плесени немедленно обратитесь за профессиональной помощью - не пытайтесь исправить это, рискуя распространить проблему.
- Очистите, продезинфицируйте или уберите из дома все предметы, которые могли подвергнуться воздействию плесени, чтобы убить блуждающие споры и предотвратить повторение проблемы.
- Для более серьезных проблем домовладельцы могут связаться со своей страховой компанией, чтобы узнать, покрывает ли их страховка домовладельцев плесень. Иногда страховка домовладельцев покрывает плесень, но обычно только в том случае, если ее вызывает покрываемый риск, и только в каждом конкретном случае. Если второй рост плесени возникает в результате неустраненного повреждения водой или неустраненной утечки, он не будет покрыт, а плесень, возникшая в результате наводнения, может не быть покрыта в некоторых районах, если домовладелец также не застрахован от наводнения.
- Соберите оценки от нескольких авторитетных компаний по устранению плесени, но не выбирайте автоматически самую дешевую цену. Действительно сравните услуги, предлагаемые каждой компанией, и проверьте рекомендации. Низкая стоимость может отражать нестандартные или упрощенные процедуры, меньшую защиту дома и технических специалистов или меньший опыт.

Вопросы об устранении плесени
Важно получить ответы на несколько вопросов, прежде чем нанимать профессиональную компанию по восстановлению. Во-первых, это хорошая идея, чтобы выбрать компанию, которая специализируется на устранении плесени. Первоначальные затраты могут показаться выше, чем у профессионалов, которые занимаются другими строительными работами или ремонтом дома, но компания, которая специализируется на устранении плесени, также с большей вероятностью будет иметь опыт для более эффективной защиты своих работников, и у нее может быть более реалистичная первоначальная стоимость. оценить, потому что он знает, что ожидать во время работы. Имейте под рукой эти вопросы, прежде чем искать «лечение плесени рядом со мной»:
- Включено ли тестирование до и после исправления в стоимость?
- Вы будете работать с независимым инспектором, если я предпочту нанять своего собственного?
- У вас есть страховка от плесени?
- Какие сертификаты есть у ваших технических специалистов? Сертификация по ликвидации плесени, борьбе с асбестом и вывозу опасных отходов - все это разумные ожидания.
- Какую защиту будут носить ваши технические специалисты? Какую защиту вы обеспечите для моего дома?
- Что входит в договор? Оценка плесени, локализация, удаление поврежденных и пористых материалов, дезинфекция поверхности всей территории, и HEPA-пылесос и очистка воздуха - все это разумные элементы контракта.
- Могу ли я нанять отдельных специалистов для выполнения восстановительных работ или сделать это самостоятельно после завершения процесса восстановления?
- Основываясь на вашей оценке, с какими потенциальными сюрпризами мы можем столкнуться? Как будут оцениваться и управляться дополнительные расходы?
- Каковы сроки восстановления, и можем ли мы оставаться дома, пока он проводится?
Часто задаваемые вопросы
Обнаружение плесени может быть шокирующим, особенно если масштабы проблемы не очевидны. Опасения и вопросы, касающиеся последствий для здоровья, вариантов и решений, которые необходимо сделать в отношении того, как решить проблему, а также финансовые последствия работы, которую необходимо выполнить, вполне понятны. Это одни из первых вопросов, которые возникают у многих людей, когда они обнаруживают плесень в своем доме, а также ответы на них, чтобы развеять некоторые первоначальные страхи.
Q. Можно ли удалить всю плесень из моего дома?
Нет. Плесень везде - в воздухе, на поверхностях и в ткани. Он имеет решающее значение для окружающей среды, поскольку переваривает и удаляет разлагающийся материал. Каждый день мы сосуществуем со всеми видами плесени, большинство из которых относительно безвредны. Вот почему тесты, доступные в хозяйственном магазине, не самые полезные; они всегда покажут наличие плесени, а не помогут определить, присутствует ли слишком много плесени или какая-то конкретная опасная плесень. Беспокойство и потребность в исправлении возникает, когда в определенной области распространяется более крупный рост плесени, создавая концентрацию спор и превращаясь в колонию, которая производит больше спор, что в конечном итоге повлияет на строительные конструкции и здоровье жителей.
Q. Безопасно ли мне оставаться дома во время процесса устранения плесени?
В большинстве случаев да, но это зависит от объема исправления. Профессиональная компания по устранению плесени изолирует область, чтобы предотвратить перенос спор в другие части дома, а технические специалисты должны запустить воздухоочистители и скрубберы, прежде чем вскрывать область и безопасно утилизировать материалы. Если рост происходит более чем в одной области или в основной части дома, может быть удобнее оставаться в другом месте во время процесса. Шум может повлиять на это решение, как и время года; если сейчас зима и из-за постоянной вентиляции в доме будет холодно, возможно, стоит остановиться на несколько дней в другом месте.
Q. Могу ли я удалить плесень самостоятельно?
Если рост плесени составляет менее 10 квадратных футов, он заметен, имеет явный источник влаги, который легко устранить, и он доступен, большинство домовладельцев могут использовать имеющийся в продаже спрей для удаления плесени, чтобы убить и удалите плесень в соответствии с рекомендациями EPA. Рекомендуется надлежащее защитное снаряжение, включая респиратор, защитные очки и перчатки, как для защиты от плесени, так и от агрессивных химикатов в продукте для удаления.
Q. Может ли плесень вызвать проблемы со здоровьем?
Краткий ответ - да. Хотя не все формы вредны, споры некоторых разновидностей могут быть токсичными для человека. Это может включать респираторные симптомы, такие как кашель или затрудненное дыхание, или может также проявляться в виде кожной сыпи и сенной лихорадки. Эти симптомы, как правило, усиливаются у людей с ослабленной иммунной системой, аллергией или астмой.
Q. Как узнать, есть ли в моем доме плесень?
Иногда плесень очевидна - ее могут выдать видимые ростки на стенах или потолках или отчетливый затхлый запах. Но в других случаях плесень более неуловима. Чаще всего плесень можно найти в домах, где были повреждения водой или чрезмерная влажность. Даже если плесень не видна, если дом поврежден водой или жители испытывают симптомы воздействия плесени, стоит потратить средства на проверку плесени, чтобы определить, есть ли рост плесени где-либо в доме.
